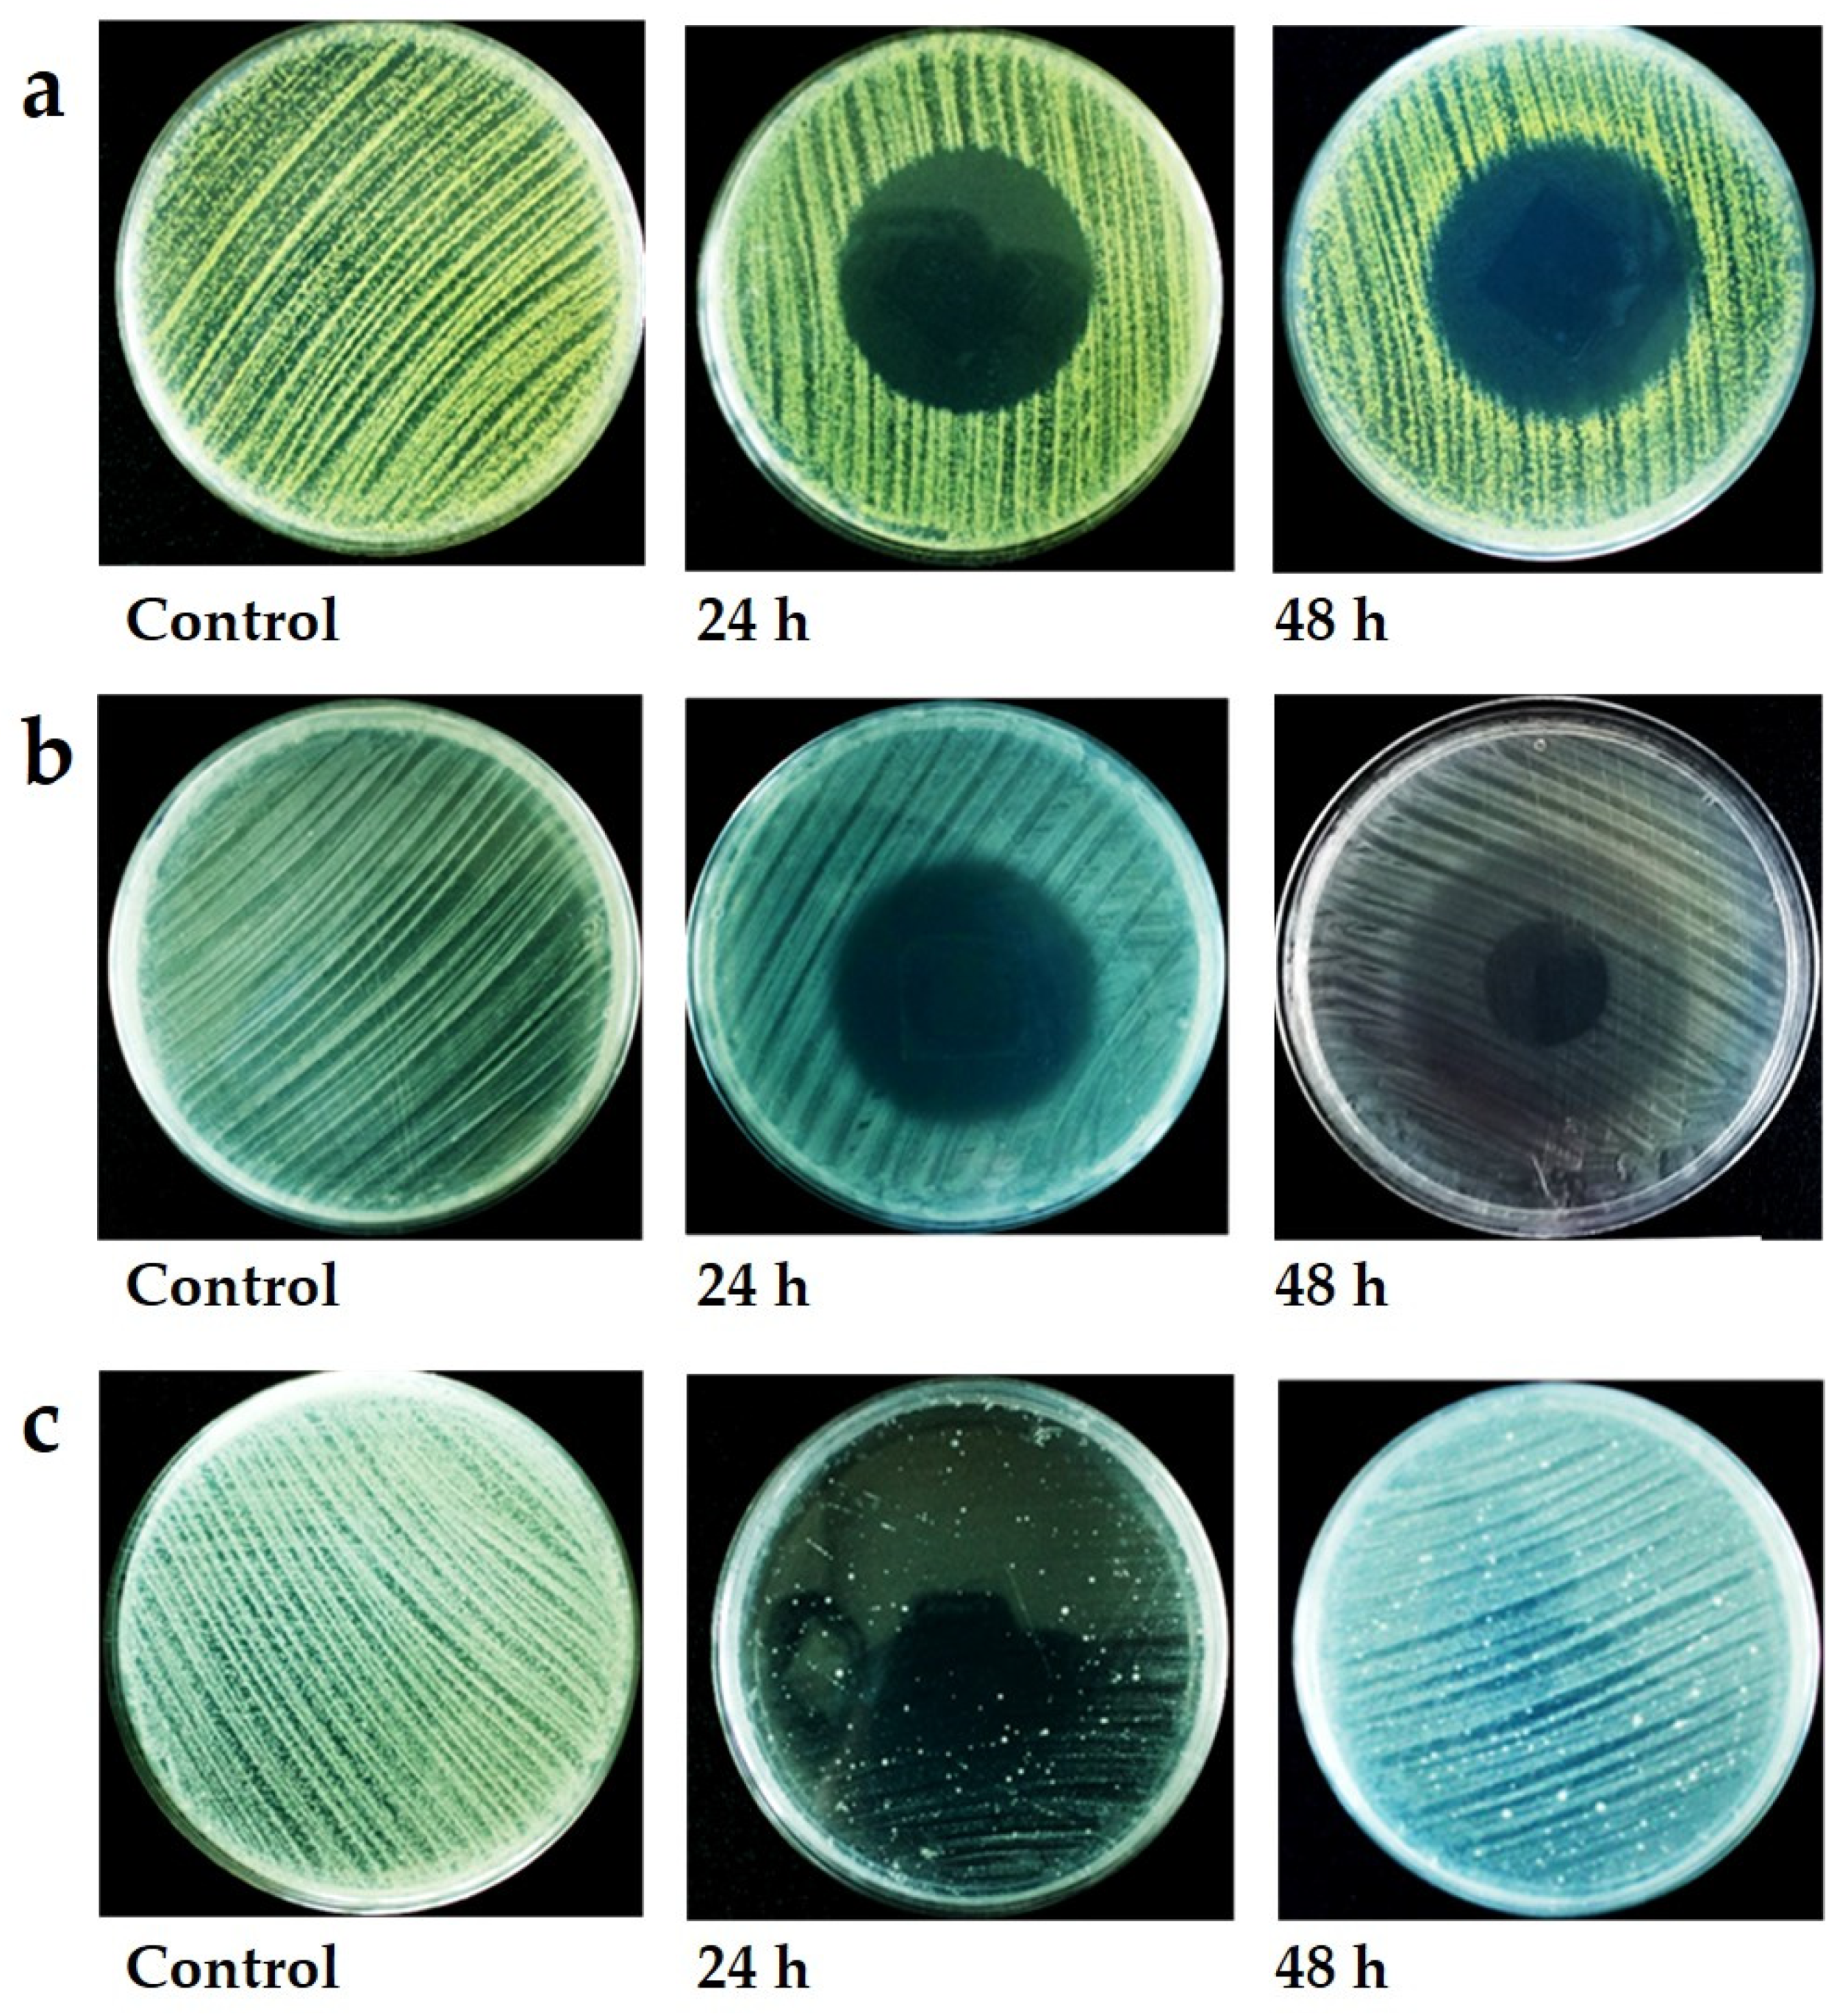

Antimicrobial Volatiles of the Insect Pathogen Metarhizium brunneum
Abstract
:1. Introduction
2. Materials and Methods
2.1. M. brunneum Isolates and Culture Conditions for Collecting VOCs
2.2. Collection and Identification M. brunneum VOCs
2.3. Evaluation of VOC Antimicrobial Activity
2.4. Scanning Electron Microscopy (SEM)
2.5. Data Handling
3. Results
3.1. VOC Profiles Were Influenced by Strain and Culture Medium
3.2. VOC Antibacterial and Antifungal Activity
4. Discussion
Supplementary Materials
Author Contributions
Funding
Institutional Review Board Statement
Informed Consent Statement
Data Availability Statement
Conflicts of Interest
References
- Behie, S.W.; Moreira, C.C.; Sementchoukova, I.; Barelli, L.; Zelisko, P.M.; Bidochka, M.J. Carbon translocation from a plant to an insect-pathogenic endophytic fungus. Nat. Commun. 2017, 8, 14245. [Google Scholar] [CrossRef] [PubMed] [Green Version]
- Scheepmaker, J.W.A.; Butt, T.M. Natural and released inoculum levels of entomopathogenic fungal biocontrol agents in soil in relation to risk assessment and in accordance with EU regulations. Biocontrol Sci. Technol. 2010, 20, 503–552. [Google Scholar] [CrossRef]
- Wang, C.; Hu, G.; St. Leger, R.J. Differential gene expression by Metarhizium anisopliae growing in root exudate and host (Manduca sexta) cuticle or hemolymph reveals mechanisms of physiological adaptation. Fungal Genet. Biol. 2005, 42, 704–718. [Google Scholar] [CrossRef] [PubMed]
- Wyrebek, M.; Huber, C.; Sasan, R.K.; Bidochka, M.J. Three sympatrically occurring species of Metarhizium show plant rhizosphere specificity. Microbiology 2011, 157, 2904–2911. [Google Scholar] [CrossRef] [PubMed] [Green Version]
- Qu, Q.; Li, Y.; Zhang, Z.; Cui, H.; Zhao, Q.; Liu, W.; Lu, T.; Qian, H. Effects of S-metolachlor on wheat (Triticum aestivum L.) seedling root exudates and the rhizosphere microbiome. J. Hazard. Mater. 2021, 411, 125137. [Google Scholar] [CrossRef] [PubMed]
- Barelli, L.; Moreira, C.C.; Bidochka, M.J. Initial stages of endophytic colonization by Metarhizium involves rhizoplane colonization. Microbiology 2018, 164, 1531–1540. [Google Scholar] [CrossRef]
- Sasan, R.K.; Bidochka, M.J. The insect-pathogenic fungus Metarhizium robertsii (Clavicipitaceae) is also an endophyte that stimulates plant root development. Am. J. Bot. 2012, 99, 101–107. [Google Scholar] [CrossRef]
- Liao, X.; O’Brien, T.R.; Fang, W.; St. Leger, R.J. The plant beneficial effects of Metarhizium species correlate with their association with roots. Appl. Microbiol. Biotechnol. 2014, 98, 7089–7096. [Google Scholar] [CrossRef]
- Ahmad, I.; Jiménez-Gasco, M.D.M.; Luthe, D.S.; Shakeel, S.N.; Barbercheck, M.E. Endophytic Metarhizium robertsii promotes maize growth, suppresses insect growth, and alters plant defense gene expression. Biol. Control 2020, 144, 104167. [Google Scholar] [CrossRef]
- Sasan, R.K.; Bidochka, M.J. Antagonism of the endophytic insect pathogenic fungus Metarhizium robertsii against the bean plant pathogen Fusarium solani f. sp. phaseoli. Can. J. Plant Pathol. 2013, 35, 288–293. [Google Scholar] [CrossRef]
- Khan, A.L.; Hamayun, M.; Khan, S.A.; Kang, S.-M.; Shinwari, Z.K.; Kamran, M.; ur Rehman, S.; Kim, J.-G.; Lee, I.-J. Pure culture of Metarhizium anisopliae LHL07 reprograms soybean to higher growth and mitigates salt stress. World J. Microbiol. Biotechnol. 2012, 28, 1483–1494. [Google Scholar] [CrossRef] [PubMed]
- Garbeva, P.; Hordijk, C.; Gerards, S.; de Boer, W. Volatiles produced by the mycophagous soil bacterium Collimonas. FEMS Microbiol. Ecol. 2014, 87, 639–649. [Google Scholar] [CrossRef] [PubMed] [Green Version]
- Kai, M.; Effmert, U.; Berg, G.; Piechulla, B. Volatiles of bacterial antagonists inhibit mycelial growth of the plant pathogen Rhizoctonia solani. Arch. Microbiol. 2007, 187, 351–360. [Google Scholar] [CrossRef]
- Vespermann, A.; Kai, M.; Piechulla, B. Rhizobacterial Volatiles Affect the Growth of Fungi and Arabidopsis thaliana. Appl. Environ. Microbiol. 2007, 73, 5639–5641. [Google Scholar] [CrossRef] [PubMed] [Green Version]
- López, S.M.Y.; Pastorino, G.N.; Balatti, P.A. Volatile organic compounds profile synthesized and released by endophytes of tomato (Solanum lycopersici L.) and their antagonistic role. Arch. Microbiol. 2021, 203, 1383–1397. [Google Scholar] [CrossRef]
- Kai, M.; Haustein, M.; Molina, F.; Petri, A.; Scholz, B.; Piechulla, B. Bacterial volatiles and their action potential. Appl. Microbiol. Biotechnol. 2009, 81, 1001–1012. [Google Scholar] [CrossRef] [PubMed]
- Hagai, E.; Dvora, R.; Havkin-Blank, T.; Zelinger, E.; Porat, Z.; Schulz, S.; Helman, Y. Surface-motility induction, attraction and hitchhiking between bacterial species promote dispersal on solid surfaces. ISME J. 2014, 8, 1147–1151. [Google Scholar] [CrossRef] [Green Version]
- Lee, S.; Behringer, G.; Hung, R.; Bennett, J. Effects of fungal volatile organic compounds on Arabidopsis thaliana growth and gene expression. Fungal Ecol. 2019, 37, 1–9. [Google Scholar] [CrossRef]
- Schmidt, R.; Cordovez, V.; de Boer, W.; Raaijmakers, J.; Garbeva, P. Volatile affairs in microbial interactions. ISME J. 2015, 9, 2329–2335. [Google Scholar] [CrossRef] [Green Version]
- Schulz-Bohm, K.; Geisen, S.; Wubs, E.R.J.; Song, C.; de Boer, W.; Garbeva, P. The prey’s scent—Volatile organic compound mediated interactions between soil bacteria and their protist predators. ISME J. 2017, 11, 817–820. [Google Scholar] [CrossRef] [Green Version]
- Wu, Y.; Zhou, J.; Li, C.; Ma, Y. Antifungal and plant growth promotion activity of volatile organic compounds produced by Bacillus amyloliquefaciens. MicrobiologyOpen 2019, 8, e00813. [Google Scholar] [CrossRef] [PubMed] [Green Version]
- Hussain, A.; Tian, M.-Y.; He, Y.-R.; Lei, Y.-Y. Differential fluctuation in virulence and VOC profiles among different cultures of entomopathogenic fungi. J. Invertebr. Pathol. 2010, 104, 166–171. [Google Scholar] [CrossRef] [PubMed]
- Mburu, D.M.; Maniania, N.K.; Hassanali, A. Comparison of Volatile Blends and Nucleotide Sequences of Two Beauveria Bassiana Isolates of Different Virulence and Repellency towards the Termite Macrotermes Michealseni. J. Chem. Ecol. 2013, 39, 101–108. [Google Scholar] [CrossRef] [PubMed]
- Butt, T.M.; Coates, C.J.; Dubovskiy, I.M.; Ratcliffe, N.A. Entomopathogenic Fungi: New Insights into Host–Pathogen Interactions. Adv. Genet. 2016, 94, 307–364. [Google Scholar] [PubMed]
- Bojke, A.; Tkaczuk, C.; Stepnowski, P.; Gołębiowski, M. Comparison of volatile compounds released by entomopathogenic fungi. Microbiol. Res. 2018, 214, 129–136. [Google Scholar] [CrossRef] [PubMed]
- Khoja, S.; Eltayef, K.M.; Baxter, I.; Bull, J.C.; Loveridge, E.J.; Butt, T. Fungal volatile organic compounds show promise as potent molluscicides. Pest Manag. Sci. 2019, 75, 3392–3404. [Google Scholar] [CrossRef] [Green Version]
- Hummadi, E.H.; Dearden, A.; Generalovic, T.; Clunie, B.; Harrott, A.; Cetin, Y.; Demirbek, M.; Khoja, S.; Eastwood, D.; Dudley, E.; et al. Volatile organic compounds of Metarhizium brunneum influence the efficacy of entomopathogenic nematodes in insect control. Biol. Control 2021, 155, 104527. [Google Scholar] [CrossRef]
- Dromph, K.M.; Vestergaard, S. Pathogenicity and attractiveness of entomopathogenic hyphomycete fungi to collembolans. Appl. Soil Ecol. 2002, 21, 197–210. [Google Scholar] [CrossRef]
- Dromph, K.M. Collembolans as vectors of entomopathogenic fungi. Pedobiologia 2003, 47, 245–256. [Google Scholar] [CrossRef]
- Mburu, D.M.; Ochola, L.; Maniania, N.K.; Njagi, P.G.N.; Gitonga, L.M.; Ndung’U, M.W.; Wanjoya, A.K.; Hassanali, A. Relationship between virulence and repellency of entomopathogenic isolates of Metarhizium anisopliae and Beauveria bassiana to the termite Macrotermes michaelseni. J. Insect Physiol. 2009, 55, 774–780. [Google Scholar] [CrossRef]
- Pereira, H.; Detrain, C. Pathogen avoidance and prey discrimination in ants. R. Soc. Open Sci. 2020, 7, 191705. [Google Scholar] [CrossRef] [PubMed] [Green Version]
- Shah, F.A.; Wang, C.S.; Butt, T.M. Nutrition influences growth and virulence of the insect-pathogenic fungus Metarhizium anisopliae. FEMS Microbiol. Lett. 2005, 251, 259–266. [Google Scholar] [CrossRef] [PubMed] [Green Version]
- Pöchlauer, P.; Hendel, W.; Burger, C.; Lamplmayr, A.; Pöschko, H.; Praus, A.; Summer, G. Process for the Preparation of Carboxylic Acid Succinimidyl Esters. U.S. Patent 5,734,064, 31 March 1998. [Google Scholar]
- López, P.; Sánchez, C.; Batlle, R.; Nerín, C. Solid- and Vapor-Phase Antimicrobial Activities of Six Essential Oils: Susceptibility of Selected Foodborne Bacterial and Fungal Strains. J. Agric. Food Chem. 2005, 53, 6939–6946. [Google Scholar] [CrossRef] [PubMed]
- Andrews, J.M. BSAC Methods for Antimicrobial Susceptibility Testing. (Version 12); British Society for Antimicrobial Chemotherapy: Birmingham, UK, 2013. [Google Scholar]
- Clinical and Laboratory Standards Institute (CLSI). Reference Method for Antifungal Disk Diffusion Susceptibility Testing of Yeasts. In Approved Guideline, 2nd ed.; CLSI Document M44-A2; Clinical and Laboratory Standards Institute: Wayne, PA, USA, 2009. [Google Scholar]
- Zainuddin, N.; Alias, S.A.; Lee, C.W.; Ebel, R.; Othman, N.A.; Mukhtar, M.R.; Awang, K. Antimicrobial activities of marine fungi from Malaysia. Bot. Mar. 2010, 53, 507–513. [Google Scholar] [CrossRef] [Green Version]
- Dotaona, R.; Wilson, B.A.L.; Ash, G.J.; Holloway, J.; Stevens, M.M. Sweetpotato weevil, Cylas formicarius (Fab.) (Coleoptera: Brentidae) avoids its host plant when a virulent Metarhizium anisopliae isolate is present. J. Invertebr. Pathol. 2017, 148, 67–72. [Google Scholar] [CrossRef] [PubMed]
- Jaber, L.R.; Ownley, B.H. Can we use entomopathogenic fungi as endophytes for dual biological control of insect pests and plant pathogens? Biol. Control 2018, 116, 36–45. [Google Scholar] [CrossRef]
- Siri-Udom, S.; Suwannarach, N.; Lumyong, S. Applications of volatile compounds acquired from Muscodor heveae against white root rot disease in rubber trees (Hevea brasiliensis Müll. Arg.) and relevant allelopathy effects. Fungal Biol. 2017, 121, 573–581. [Google Scholar] [CrossRef]
- Liarzi, O.; Bar, E.; Lewinsohn, E.; Ezra, D. Use of the Endophytic Fungus Daldinia cf. concentrica and Its Volatiles as Bio-Control Agents. PLoS ONE 2016, 11, e0168242. [Google Scholar] [CrossRef] [Green Version]
- Sánchez-Ortiz, B.L.; Sánchez-Fernández, R.E.; Duarte, G.; Lappe-Oliveras, P.; Macías-Rubalcava, M.L. Antifungal, anti-oomycete and phytotoxic effects of volatile organic compounds from the endophytic fungus Xylaria sp. strain PB3f3 isolated from Haematoxylon brasiletto. J. Appl. Microbiol. 2016, 120, 1313–1325. [Google Scholar] [CrossRef] [Green Version]
- Fialho, M.B.; De Moraes, M.H.D.; Tremocoldi, A.R.; Pascholati, S.F. Potential of antimicrobial volatile organic compounds to control Sclerotinia sclerotiorum in bean seeds. Pesqui. Agropecuária Bras. 2011, 46, 137–142. [Google Scholar] [CrossRef] [Green Version]
- Parafati, L.; Vitale, A.; Restuccia, C.; Cirvilleri, G. Biocontrol ability and action mechanism of food-isolated yeast strains against Botrytis cinerea causing post-harvest bunch rot of table grape. Food Microbiol. 2015, 47, 85–92. [Google Scholar] [CrossRef] [PubMed]
- Dalilla, C.R.; Mauricio, B.F.; Simone, C.B.; Silvia, B.; Sergio, F.P. Antimicrobial activity of volatile organic compounds and their effect on lipid peroxidation and electrolyte loss in Colletotrichum gloeosporioides and Colletotrichum acutatum mycelia. Afr. J. Microbiol. Res. 2015, 9, 1527–1535. [Google Scholar] [CrossRef]
- Toffano, L.; Fialho, M.B.; Pascholati, S.F. Potential of fumigation of orange fruits with volatile organic compounds produced by Saccharomyces cerevisiae to control citrus black spot disease at postharvest. Biol. Control 2017, 108, 77–82. [Google Scholar] [CrossRef]
- El-Hasan, A.; Buchenauer, H. Actions of 6-Pentyl-alpha-pyrone in Controlling Seedling Blight Incited by Fusarium moniliforme and Inducing Defence Responses in Maize. J. Phytopathol. 2009, 157, 697–707. [Google Scholar] [CrossRef]
- Robinson, P.M.; McKee, N.D.; Thompson, L.A.A.; Harper, D.B.; Hamilton, J.T.G. Autoinhibition of germination and growth in Geotrichum candidum. Mycol. Res. 1989, 93, 214–222. [Google Scholar] [CrossRef]
- Mitchell, A.M.; Strobel, G.A.; Moore, E.; Robison, R.; Sears, J. Volatile antimicrobials from Muscodor crispans, a novel endophytic fungus. Microbiology 2010, 156, 270–277. [Google Scholar] [CrossRef] [Green Version]
- Bennett, J.W.; Inamdar, A.A. Are Some Fungal Volatile Organic Compounds (VOCs) Mycotoxins? Toxins 2015, 7, 3785–3804. [Google Scholar] [CrossRef] [Green Version]
- Hung, R.; Lee, S.; Bennett, J.W. Fungal volatile organic compounds and their role in ecosystems. Appl. Microbiol. Biotechnol. 2015, 99, 3395–3405. [Google Scholar] [CrossRef]
- Chitarra, G.S.; Abee, T.; Rombouts, F.M.; Posthumus, M.A.; Dijksterhuis, J. Germination of Penicillium paneum Conidia Is Regulated by 1-Octen-3-ol, a Volatile Self-Inhibitor. Appl. Environ. Microbiol. 2004, 70, 2823–2829. [Google Scholar] [CrossRef] [Green Version]
- Wang, J.; Li, M.; Zheng, F.; Niu, C.; Liu, C.; Li, Q.; Sun, J. Cell wall polysaccharides: Before and after autolysis of brewer’s yeast. World J. Microbiol. Biotechnol. 2018, 34, 137. [Google Scholar] [CrossRef]
- Barelli, L.; Waller, A.S.; Behie, S.W.; Bidochka, M.J. Plant microbiome analysis after Metarhizium amendment reveals increases in abundance of plant growth-promoting organisms and maintenance of disease-suppressive soil. PLoS ONE 2020, 15, e0231150. [Google Scholar] [CrossRef] [PubMed]
- Tyc, O.; Song, C.; Dickschat, J.S.; Vos, M.; Garbeva, P. The Ecological Role of Volatile and Soluble Secondary Metabolites Produced by Soil Bacteria. Trends Microbiol. 2017, 25, 280–292. [Google Scholar] [CrossRef] [PubMed]
- St. Leger, R.J.; Wang, J.B. Metarhizium: Jack of all trades, master of many. Open Biol. 2020, 10, 200307. [Google Scholar] [CrossRef] [PubMed]

Publisher’s Note: MDPI stays neutral with regard to jurisdictional claims in published maps and institutional affiliations. |
© 2022 by the authors. Licensee MDPI, Basel, Switzerland. This article is an open access article distributed under the terms and conditions of the Creative Commons Attribution (CC BY) license (https://creativecommons.org/licenses/by/4.0/).
Share and Cite
Hummadi, E.H.; Cetin, Y.; Demirbek, M.; Kardar, N.M.; Khan, S.; Coates, C.J.; Eastwood, D.C.; Dudley, E.; Maffeis, T.; Loveridge, J.; et al. Antimicrobial Volatiles of the Insect Pathogen Metarhizium brunneum. J. Fungi 2022, 8, 326. https://doi.org/10.3390/jof8040326
Hummadi EH, Cetin Y, Demirbek M, Kardar NM, Khan S, Coates CJ, Eastwood DC, Dudley E, Maffeis T, Loveridge J, et al. Antimicrobial Volatiles of the Insect Pathogen Metarhizium brunneum. Journal of Fungi. 2022; 8(4):326. https://doi.org/10.3390/jof8040326
Chicago/Turabian StyleHummadi, Esam Hamid, Yarkin Cetin, Merve Demirbek, Nadeems M. Kardar, Shazia Khan, Christopher J. Coates, Daniel C. Eastwood, Ed Dudley, Thierry Maffeis, Joel Loveridge, and et al. 2022. "Antimicrobial Volatiles of the Insect Pathogen Metarhizium brunneum" Journal of Fungi 8, no. 4: 326. https://doi.org/10.3390/jof8040326
APA StyleHummadi, E. H., Cetin, Y., Demirbek, M., Kardar, N. M., Khan, S., Coates, C. J., Eastwood, D. C., Dudley, E., Maffeis, T., Loveridge, J., & Butt, T. M. (2022). Antimicrobial Volatiles of the Insect Pathogen Metarhizium brunneum. Journal of Fungi, 8(4), 326. https://doi.org/10.3390/jof8040326

